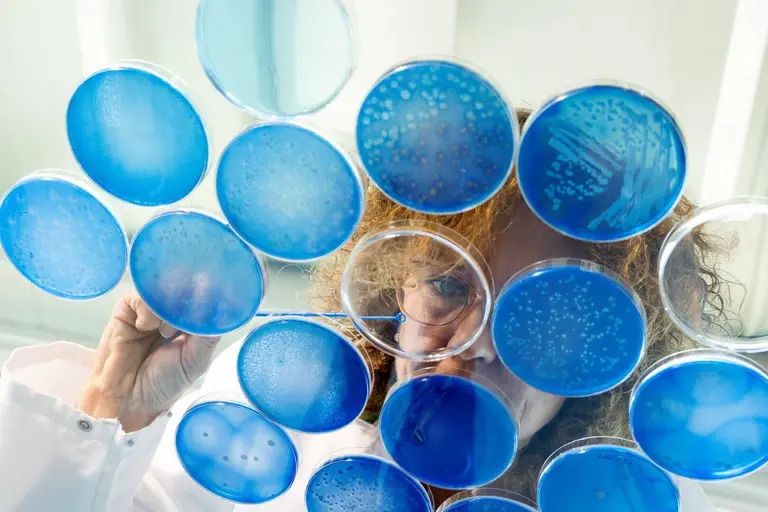
Bioscience and Biotechnology Scientific Innovation | IFF

マイストア
変更
お店で受け取る
(送料無料)
配送する
納期目安:
2026.02.18 7:19頃のお届け予定です。
決済方法が、クレジット、代金引換の場合に限ります。その他の決済方法の場合はこちらをご確認ください。
※土・日・祝日の注文の場合や在庫状況によって、商品のお届けにお時間をいただく場合がございます。
最終在庫✨新品未開封✨BIOTECH BIO WITH ONE βS 6本セット Bio-Shield Adulteration Goat - ProGnosis Biotechの詳細情報
Bio-Shield Adulteration Goat - ProGnosis Biotech。Deluxe Biology Bundle – Easy Peasy Science。Bioscience and Biotechnology Scientific Innovation | IFF。バイオテック バイオウィズワン ベータS✨【種類】薬用育毛剤【容量】300ml×6本 新品未開封品✨箱の若干のへこみや傷等はご容赦下さい。おまけ付き‼️全てシュリンク付き未開封BOX!ピカピカBOX。使用時に使う透明のミニボトル付属✨性別···男性向け
ベストセラーランキングです
近くの売り場の商品
カスタマーレビュー
オススメ度 4.1点
現在、5491件のレビューが投稿されています。